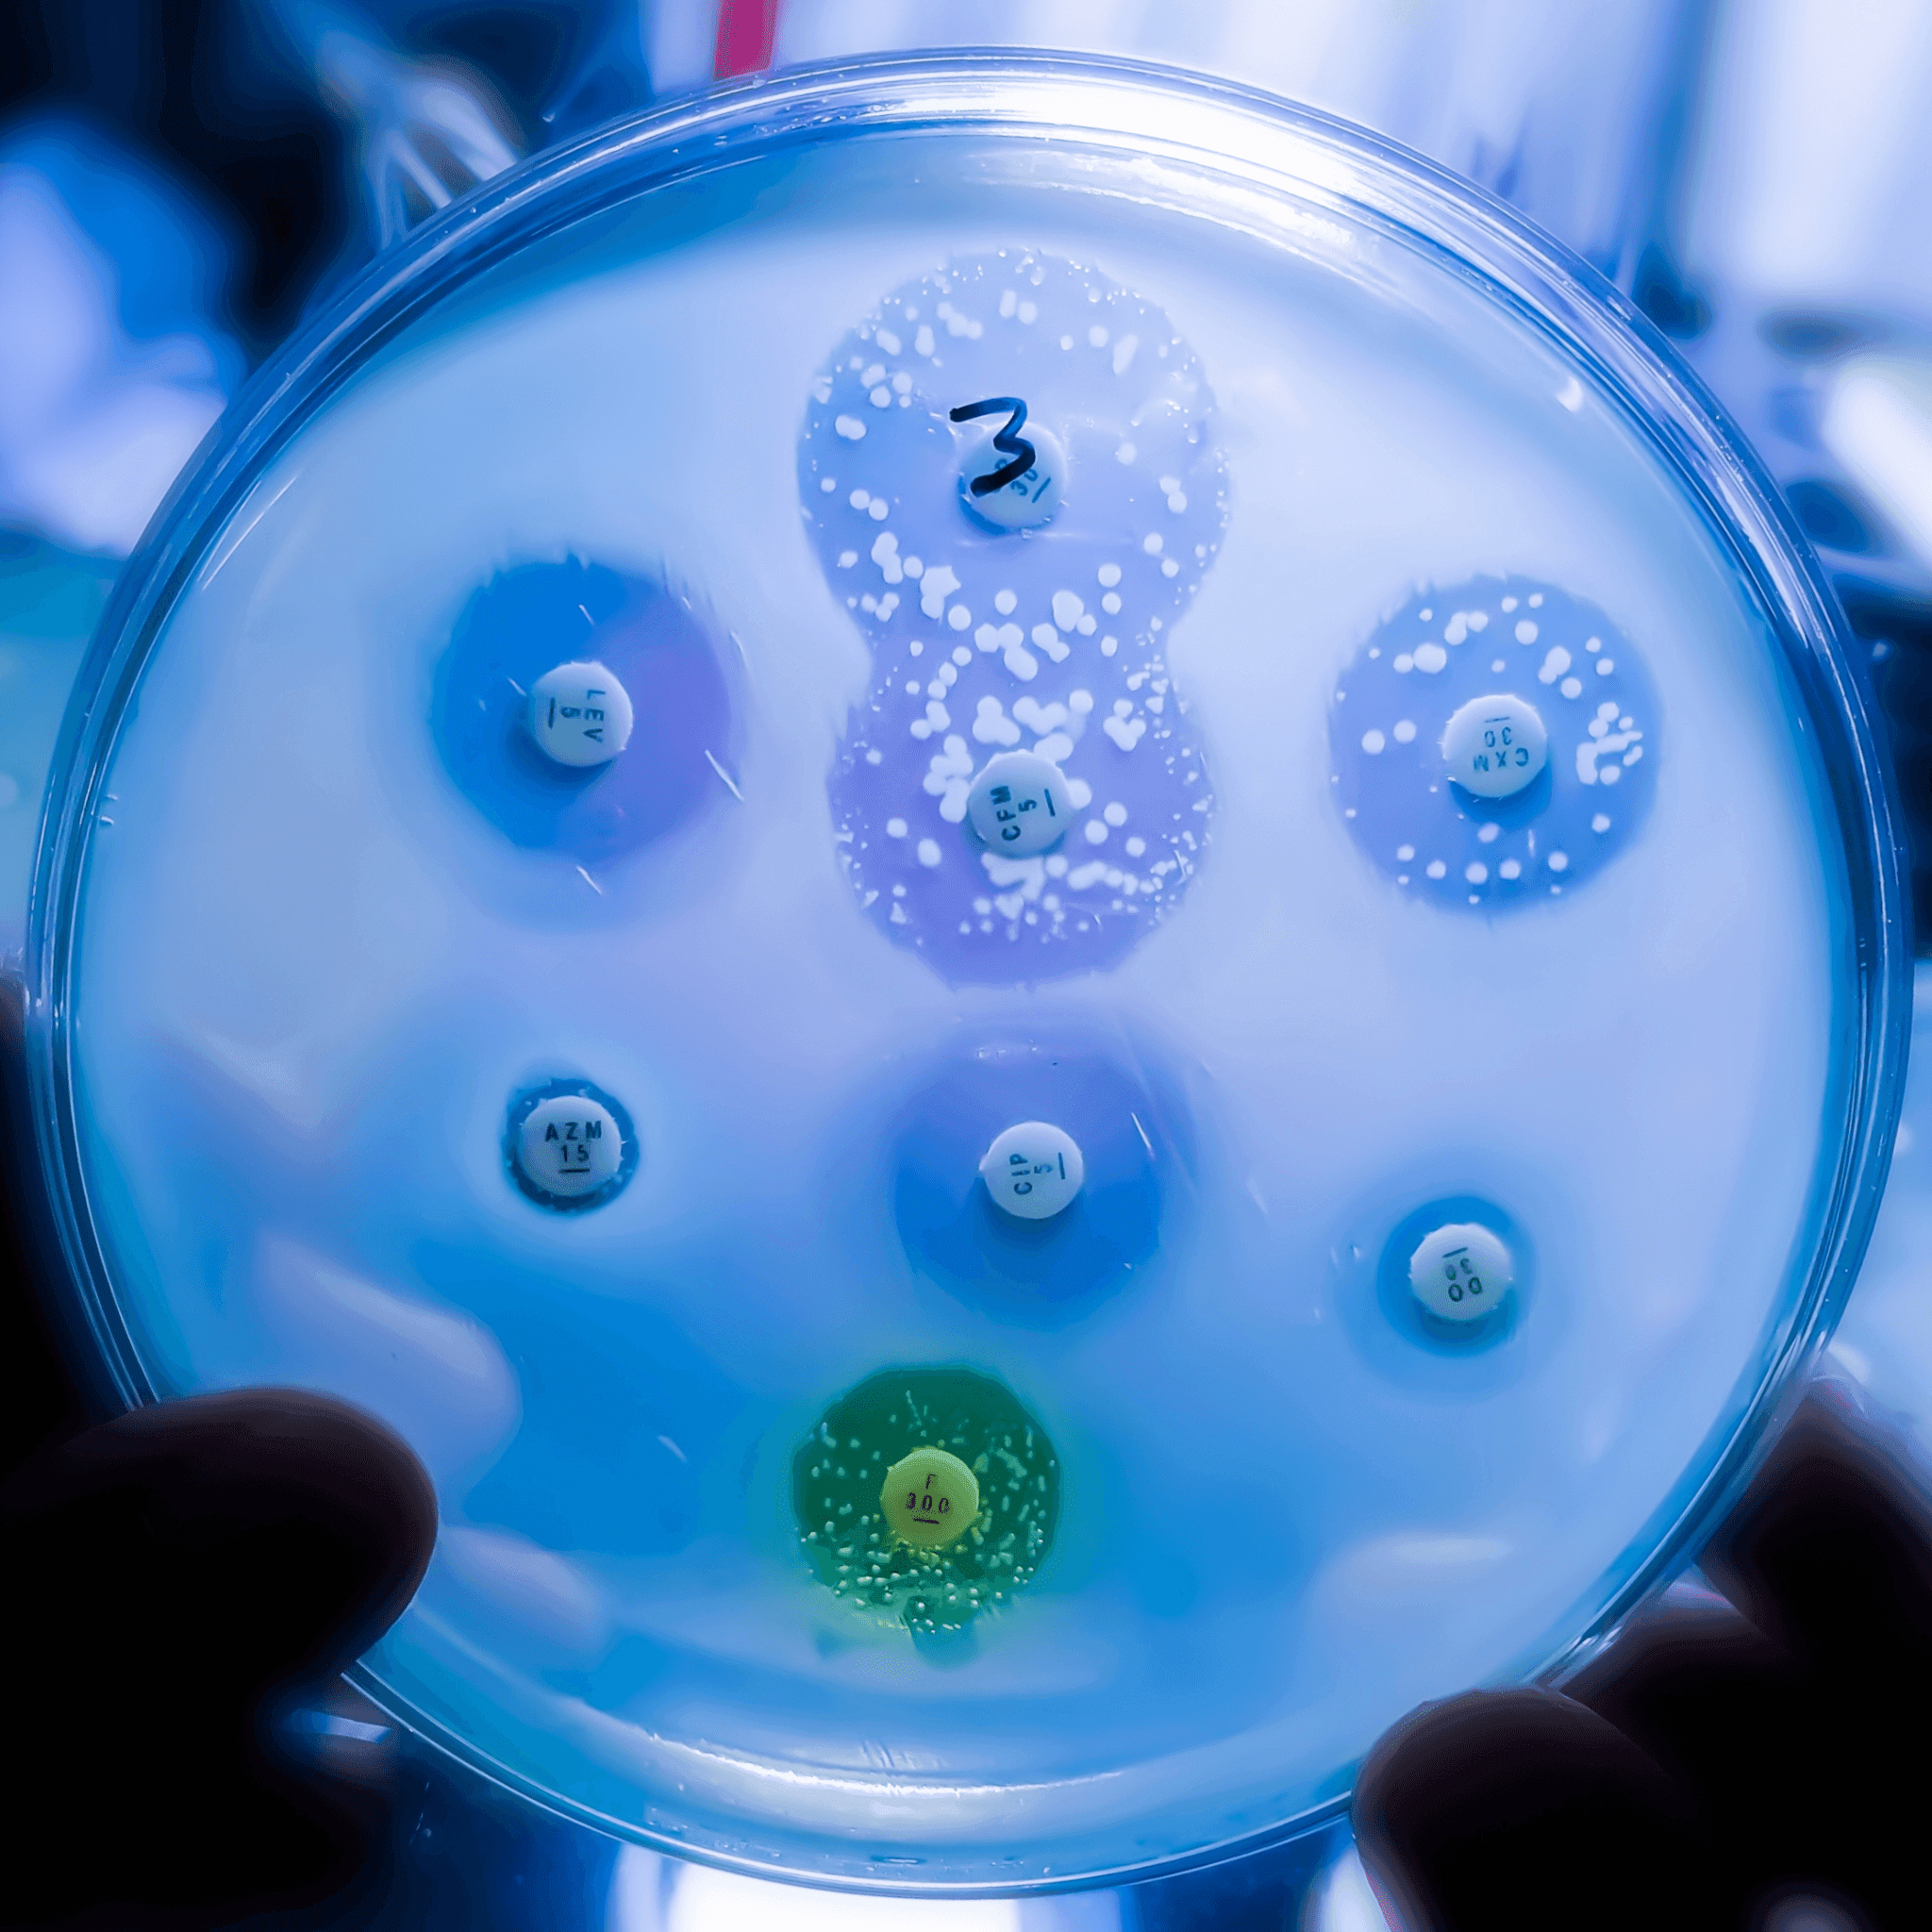

BFM 89.9
The Business Station
Copyright © 2025 BFM Media Sdn. Bhd. 200601017962. All rights reserved
Copyright © 2025 BFM Media Sdn. Bhd. 200601017962. All rights reserved
BFM 89.9
The Business Station
Copyright © 2025 BFM Media Sdn. Bhd. 200601017962. All rights reserved
Copyright © 2025 BFM Media Sdn. Bhd. 200601017962. All rights reserved

When Antimicrobial Resistance Intersects With Chronic Diseases

When Antimicrobial Resistance Intersects With Chronic Diseases
Recommended
26 mins
23 mins
26 mins
Guest: Dato' Dr Suresh Kumar Chidambaram, Consultant Infectious Diseases Physician
Antimicrobial resistance is one of the most pressing threats we face to human health, because it makes diseases much more difficult, if not impossible, to treat. It means the risk of the disease spreading is higher, and thus more severe illness and even death. In a society where much of the population lives with chronic disease, the burden of AMR is even worse and complicates the care for these patients. In conjunction with World Antimicrobial Awareness Week, observed annually from 18th to 24th November every year, we’ll be exploring the challenges of managing AMR when it intersects with chronic diseases with consultant infectious diseases physician Dato’ Dr Suresh Kumar Chidambaram.
Image credit: Shutterstock
Presenter: Tee Shiao Eek
Producer: Lim Sue Ann
Share:
Recommended


Recent episodes
0
Latest stories